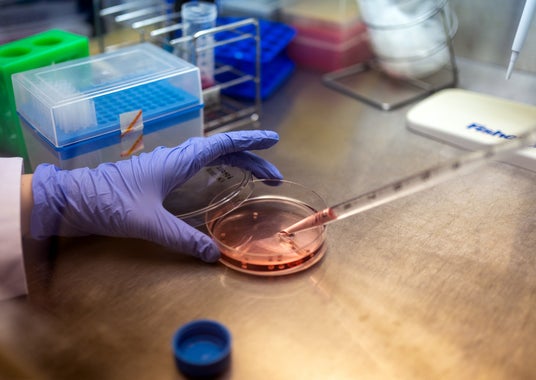

【PR TIMES 住宅・建築・建設 出版・アート・カルチャー】
虎ノ門ヒルズを舞台にクリエイター・企業の実験的なプロダクトやアートが集う新たな祭典「TOKYO PROTOTYPE」出展者決定
森ビル株式会社
~大阪・関西万博、ミラノデザインウィーク、アルスエレクトロニカなどで注目を集めた計26 組による作品が出展~

森ビル株式会社(東京都港区、代表取締役社長:辻 慎吾)が運営する、⻁ノ門ヒルズの情報発信拠点「TOKYO NODE(東京ノード)」の研究開発チーム「TOKYO NODE LAB」と日本テレビ放送網株式会社が、2026年1月29日(木)~1月31日(土)の期間に開催する、⻁ノ門ヒルズを舞台にクリエイター・企業の実験的なプロダクトやアートが集う都市型クリエイティブフェスティバル「TOKYO PROTOTYPE(東京プロトタイプ)」の出展者が決定しました。
「TOKYO PROTOTYPE」は、虎ノ門ヒルズの街なかおよびTOKYO NODEを舞台に、クリエイター・アーティスト・企業が領域を越えて集い、AI・ロボティクスなどのテクノロジーを活用した実験的なプロダクトやアートなどの「プロトタイプ」を展示する都市型クリエイティブフェスティバルです。
この度、本フェスティバルの出展者および出展内容が決定しました。大阪・関西万博やミラノデザインウィーク、アルス・エレクトロニカなど、国際的な舞台で注目を集めてきた作品をはじめ、GOOGLE HARDWARE DESIGN STUDIO や ZOZO NEXTといった企業から、東京大学や慶應義塾大学大学院などの研究機関まで、領域を越えた計26組のクリエイター、アーティスト、企業などが一堂に会します。
作品を見て楽しむだけにとどまらず、交流イベントや会場に常駐するクリエイターと来場者との対話を通じ互いに刺激し合うことで、新たな発想や次のプロトタイプへとつながる場を生み出します。年々スケールを拡張しながら、都市空間を実験場としてひらき、虎ノ門という街を舞台に、21世紀ならではの新しい「祭り」や「文化」が立ち上がる、東京発の未来を創造する場を目指します。
「TOKYO PROTOTYPE」WEBサイト:https://tokyoprototype.jp
⻁ノ門ヒルズの街なかおよび「TOKYO NODE」を舞台に、都市空間そのものを開かれた実験場として活用。街を歩く体験がそのまま鑑賞体験となる都市スケールのクリエイティブフェスティバル。
- 国際的な舞台で注目を集めてきた作品が集結
大阪・関西万博、ミラノデザインウィーク、アルス・エレクトロニカなど、世界的なイベントで注目を集めてきたアーティスト、クリエイターらによる実験的かつ先鋭的な作品が集結するほか、令和6年度文化庁メディア芸術クリエイター育成事業の支援を受けて制作された作品から2作品が出展されます。

- クリエイター・アーティスト・企業・研究機関が領域を越えて参加」
GOOGLE HARDWARE DESIGN STUDIO、ZOZO NEXTなどの企業展示に加え、東京大学 、慶應義塾大学大学院の研究機関まで、計26組の多様な出展者が一堂に会し、テクノロジーと創造性の最前線を可視化。
- AI・ロボティクスなど先端テクノロジーを活用し“未来”の提示
完成形ではなく、思考や試行のプロセスそのものを含んだ「プロトタイプ」を展示。アート、デザイン、テクノロジーが交差する実験的な挑戦を体感できます。
- クリエイター常駐による対話型の展示体験
出展者が会場に常駐。来場者は対話や交流を通じて、作品の背景や思考に直接触れることができ、新たな気づきや次なるコラボレーションが生まれる場となります。
- 年々拡張していく東京発の新しい「祭り」
都市、テクノロジー、創造性が交錯する、21 世紀ならではの文化的実験として、虎ノ門ヒルズから新しい「祭り」や「文化」の立ち上がりを発信します。
■場所:虎ノ門ヒルズ街なか各所およびTOKYO NODE
B2階 ステーションアトリウム・虎ノ門ヒルズカフェ/8階 TOKYO NODE エントランス・
TOKYO NODE LAB・TOKYO NODE CAFE/45階 TOKYO NODE アライバルホール/
46階 TOKYO NODE HALL/49階 TOKYO NODE SKY GARDEN & POOL
■時間:11:00-21:00
■料金:無料
■主催:森ビル株式会社 TOKYO NODE LAB・日本テレビ放送網株式会社
■協力:文化庁
■WEB サイト:https://tokyoprototype.jp
Human(人を起点に)。Optimistic(前向きに)。Daring(大胆に)。この3つの言葉は、Googleのハードウェアデザインチームを導く指針です。Googleのハードウェアデザインチームは、継続的なサステナビリティへの取り組みの一環として、責任ある素材を用い、長く使い続けられる、思慮深いプロダクトを生み出しています。

▮ 出展者:出展者:株式会社ZOZO NEXT
ZOZO NEXTはファッション領域におけるユーザーの課題を想像しテクノロジーの力で解決することで、より多くの人がファッションを楽しめる世界の創造を目指しています。ファッションを数値化し、科学的に解明するための研究機関「ZOZO研究所」やファッションの未来に影響を与える6領域のテーマでZOZOグループの新規事業の創出を目的とする「MATRIX」などでR&Dをおこなっています。

▮ 出展者:出展者:bit.studio
宙に浮遊する魚が生み出す、超自然を体感できます。

▮ 出展者:TASKO x Abstract Engine
「Tug of Memories」は2021年、コロナ禍で空白となった劇場において、かつての情景を演奏とともに呼び戻す“追憶の舞台装置”として製作されました。ロボットアームが物理的にピアノを手繰り寄せ、レールに記録されたデータを読み取り演奏を行う装置です。人々が集う価値が見直される現在、本作は当時の閉塞と現在の時間を重ね、過去と今の記憶が交差するレイヤーを静かに示します。

▮ 出展者:藤堂高行
鎖に繋がれたロボット犬が、人に襲いかかろうと暴れ狂う姿を、安全圏から眺める作品です。

写真クレジット:Takuma Yamazaki
▮ 出展者:池坊 / BAUMX / enigma
「いのちの多元」蓮が象徴する純粋な命と、都市に広がる多様な命の営み。その間を往復する光と視点の変化を通して、いのちの多層的な姿を体感するインスタレーションです。(いけばな作品:石渡雅史)

▮ 出展者:D2C IMG SRC STUDIO × SoVeC
IMG SRC STUDIOの自社展示「IDEATIONS」を「Satellite」としてTOKYO PROTOTYPEに展開。さらにSoVeC社と協業し、最新技術を応用した作品を制作。XRと感覚刺激による現実と仮想が相互接続する体験、生成AIと知覚的統合による多層的なXR共有体験、そしてユーザーデータや環境をサンプリングし即座にDJミックス可能な感覚拡張型コンテンツを出展します。

▮ 出展者:株式会社ミライセンス
「響き」のリレーと未来への継承~万博で184日間、無数の人々の鼓動を受け取ってきたechorbは、その“響きの遺伝子“をもって、TOKYO PROTOTYPEにやってきます。それは単なるテクノロジーの“再利用“ではなく、記憶と共鳴の継承、そして未来への飛躍です。万博が未来の都市を描いたなら、TOKYO PROTOTYPEでは“未来と文化が交差する場“として、響きによる人と人との共鳴の新しいカルチャーを定義します。

▮ 出展者:Konel Inc. / NTT DX Partner Corporation
「睡眠後進国 日本」日本人の睡眠時間は、先進国を中心とした世界33カ国の中で最下位。未だに十分な睡眠時間を得られておらず、睡眠不足による経済的な損失は計り知れません。オンライン化によって常に大量な情報に晒される現代人にとって、睡眠は世界と断絶できる唯一の時間。私たちは個人の生体データをもとに最適化された音楽と照明によって、パーソナルに眠りを持ち運ぶことができる新しい睡眠システムを提案します。

Photo by YusukeMaekawa
▮ 出展者:HAKUTEN・HAKUTEN CREATIVE
私たちHAKUTEN は、照明、マテリアル、テクノロジーなどを活用し、イベントを通じて新たな体験を創出してきました。「100+ prototypes」とは、プロジェクトの過程で生まれた試作(プロトタイプ)をアーカイブし、創造の循環を生み出すことを目指した取り組み。完成には至らなかった断片にも、試行錯誤の跡やひらめきの種が宿っています。それらを捨てずに蓄積・共有することで、別の誰かの新たな発想につなげることを目的としています。本展示ではその一部を実物展示として公開します。

▮ 出展者:乃村工藝社 未来創造研究所 NOMLAB
NOMLAB では、依頼を受けてから考え始めるのではなく、自ら想像し、これからの空間のアイデアを育てています。今回は、4つのプロトタイプの展示を行います。(Emograf:感情で人と空間をつなぐ、小さな電気でできること:自然由来の小さな電気で植物と人と空間をつなぐ、Sound Seek:音で人と空間をつなぐ、GenerativeTile:陶器とデジタルファブリケーションで空間の未来を描く)

▮ 出展者:130 onethirty | MagnaRecta.inc
中央に置かれたランプ《Helio》は、多層のグリッド構造からなる“コア(核)”として設計されています。その周囲を取り囲むのは、外装一層だけでかたちづくられた人型のマネキンたち──中身を欠いた“シェル(殻)”です。Helio は光を放つランプですが、恒星を模したその光に、人は自然と求めていく様を表現しています。放射状に広がるHelio のグリッドと、薄いシェル構造の人型との対比を通じて、「どこまでが家具で、どこからが身体なのか」「コアとシェルはどちらが主役なのか」という問いの小さなラウンジです。

▮ 出展者:PHIARO CORPORATION
デジタル開発のサンプルとしてMR(Mixed Reality)シミュレータと、リアルのプロトタイプ車両開発のサンプルとしてバギー(デザイン~EV コンポーネンなど)を、ご体感いただけます。加えて、当社の多様なプロトタイプ開発事例を、動画などを通じて幅広く紹介します。

▮ 出展者:mud Inc.
Prompt Racing は、プロンプトから生成されたマシンで競い合う、新感覚のレースゲーム。あらゆるアイデアや妄想がAI によってマシンとして具現化され、常識を超えたレースを展開します。AI の生産性向上や効率化ではなく、創造性を拡張する側面に着目し、自らの創造性がブーストしていく楽しさや喜びを提供します。

▮ 出展者:東京大学五十嵐研究室 / ソフトバンク株式会社 / Takram
「Postrace」は、ショーウィンドウなどでの使用を想定し、衣服を着用して様々なポーズをとることが出来るマネキンロボットです。展示プロトタイプでは、目の前の人の動きを真似するように動作します。人が衣服を着用したのと同じような衣服の変形やしわ、人が服を着て行う様々なポージングを再現するため、人体の自然なシルエットがなるべく崩れない関節構造や、胴体のひねり、肩や骨盤の傾きなどを変化させられる構造になっているのが特徴です。

▮ 出展者:DNP / THRUSTER / 5BLOCKS
コンテンツ・XRコミュニケーションによって、自治体・企業の「場の拡張」と「人の拡張」を実現します。本展示では「場の拡張」として、ARグラス「XREAL」を通じて、ユーザーが視聴している動画や3DCG空間などを、リアルタイムに3D変換し体験できます。また、「人の拡張」としてゲームPFであるMINECRAFTやROBLOXを活用して、職業体験や探求学習も行えます。

▮ 出展者:Abstract Engine
体験者は慣性チェアに身体を委ね、視覚と感覚だけが四足ロボットへ同期します。現実の身体は椅子にとどまりつつ、“ロボットとして振る舞うべき身体”が立ち上がり、体験者の行動パターンを感覚情報と共にデータとして収集し、フィードバックの方法を探ります。本作は、人間と機械の境界を探るプロトタイプです。
機材協賛:ヒビノ株式会社、ヒビノメディアテクニカル株式会社/機材協力 : トヨタ紡織株式会社

▮ 出展者: I.CEBERG | WOW
5名のメゾンによる主要作品と、その制作過程で生まれた個々の物語を組み合わせ、思考の内部をのぞき込むような体験を構成します。来場者は、怪物に向き合うメゾンの旅路を追体験しながら、いつのまにか自身の内側に潜む怪物と向き合うことになるでしょう。

▮ 出展者:Spline Design Hub
本作は機械式腕時計のぜんまいから着想を得た作品です。薄い金属が巻かれたその形は、単なる機構部品にとどまらず、時を駆動する力とリズムを宿す器のように思えました。そっと持ち上げるとわずかな動きを受け取り、今にも鼓動を始めるかのように揺れ動いたのです。 伸縮するアームに支えられた一枚の金属板は刻一刻と形を変え、新たな秩序を生み出し続けます。移ろう螺旋の姿は、目に見えぬ時間の輪郭を静かに描き出しています。

写真クレジット:Daisuke Ohki
▮ 出展者:IE3
1999年のiMacが四半世紀後の世界と出会う。カメラが捉えた身体はブラウン管の中で抽象的なグラフィックへと生まれ変わり、その痕跡はアーカイブとして蓄積されていく。当時では想像もできなかった表現が過去のスクリーンに現れる。技術と時代、過去と現在--重なり合わない複数の層が同期を外れたまま静かに共振する。

▮ 出展者:3 AND PROGRAM
いまは未来。AIが灯した新しい光の中で、人は働くことを忘れ、愛するものに身をゆだねる。肉体は書き換えられ、感覚は衣のようにまとわれ、魂はアバターに宿る。TORIHADA――それは感情を毛先に映す小さな星。鋭く世界に触れ、静かに孤独を抱く。そして今、新たな心の温もりを探している。その手は、あなたのものだろうか。

▮ 出展者:GOO CHOKI PAR
TOKYO PROTOTYPEのアートディレクションを起点に、その思想と視覚表現を“MOTTO(さらに、その先へ)”拡張した作品展示。未知への設計図(ブループリント)を再解釈し、静的な図面から動的な体験へと昇華させる。IE3とのコラボレーションによるPortrait Blueprinterは、来場者の顔をリアルタイムで認識し、この瞬間・この場所でしか生まれないグラフィック作品を生成します。

▮ 出展者:KMD Embodied Media | 慶應義塾大学大学院
身体と空間を拡張し、新たな体験を創造する「身体性メディア」の研究と実践。

▮ 出展者:DLX Design Lab | 東京大学
東京大学生産技術研究所 DLX Design Labと、同研究所の池内研究室による8 年間にわたる4つのバックキャスティングプロジェクトを紹介し、デザインとバイオ分子神経科学の協働から生まれた未来像を示します。

▮ 出展者:xlab(筧康明研究室)| 東京大学
素材の特性や振る舞いにテクノロジーを交差させ、質感を通してナラティブを探究する複数の作品を展示。

▮ 出展者:森田 崇文
MorphFluxは、磁性流体の形状と流れが相互に作用しながら絶えず変化する実体ディスプレイのキネティックインスタレーションです。複数の液体ピクセルが干渉し合い、形や波が絶えず変化することで、一定の状態にとどまらない様子を生み出します。液体の流動的な振る舞いを通して、結びつきと切り離しが繰り返される関係性を想起させるとともに、個々の境界を曖昧にしながら関係し合う、新たな表現のあり方を探ります。

Photo by ikenoya
詳細はWEBページをご覧ください。
「TOKYO PROTOTYPE」WEBサイト:https://tokyoprototype.jp
▮ 同時開催「攻殻機動隊展」との連動:2つの”未来”が虎ノ門で交錯
同時期にTOKYO NODE GALLERYでは、「攻殻機動隊展 ~Ghost and the Shell~」が開催されます。
期間中、虎ノ門ヒルズ一帯では、「TOKYO PROTOTYPE」が提示する未来への実験と、「攻殻機動隊展」が描き続けてきた未来社会のヴィジョンがパラレルに響き合い、都市全体を舞台にした“2つの未来の交錯”を体験いただけます。都市の現在と未来、フィクションとリアルが溶け合う、この期間だけの特別なコラボレーションです。
「攻殻機動隊展~Ghost and the Shell~」WEBサイト:
https://www.tokyonode.jp/sp/exhibition-ghostintheshell/
「虎ノ門ヒルズ ステーションタワー」の最上部に位置する新たな情報発信拠点。イベントホール、ギャラリー、レストラン、ルーフトップガーデンなどが集積する、約 10,000 平方メートル の複合発信施設です。 施設内には、ミシュランで星を獲得したシェフによるレストランや、イノベーティブなプレイヤーが集まる研究開発チーム「TOKYO NODE LAB」の活動拠点も。NODE=結節点という名のとおり、テクノロジー、アート、エンターテインメントなどあらゆる領域を超えて、最先端の体験コンテンツ、サービス、ビジネスを生み出し、世界に発信していく舞台となります。
企業プレスリリース詳細へ
PR TIMESトップへ
~大阪・関西万博、ミラノデザインウィーク、アルスエレクトロニカなどで注目を集めた計26 組による作品が出展~

森ビル株式会社(東京都港区、代表取締役社長:辻 慎吾)が運営する、⻁ノ門ヒルズの情報発信拠点「TOKYO NODE(東京ノード)」の研究開発チーム「TOKYO NODE LAB」と日本テレビ放送網株式会社が、2026年1月29日(木)~1月31日(土)の期間に開催する、⻁ノ門ヒルズを舞台にクリエイター・企業の実験的なプロダクトやアートが集う都市型クリエイティブフェスティバル「TOKYO PROTOTYPE(東京プロトタイプ)」の出展者が決定しました。
「TOKYO PROTOTYPE」は、虎ノ門ヒルズの街なかおよびTOKYO NODEを舞台に、クリエイター・アーティスト・企業が領域を越えて集い、AI・ロボティクスなどのテクノロジーを活用した実験的なプロダクトやアートなどの「プロトタイプ」を展示する都市型クリエイティブフェスティバルです。
この度、本フェスティバルの出展者および出展内容が決定しました。大阪・関西万博やミラノデザインウィーク、アルス・エレクトロニカなど、国際的な舞台で注目を集めてきた作品をはじめ、GOOGLE HARDWARE DESIGN STUDIO や ZOZO NEXTといった企業から、東京大学や慶應義塾大学大学院などの研究機関まで、領域を越えた計26組のクリエイター、アーティスト、企業などが一堂に会します。
作品を見て楽しむだけにとどまらず、交流イベントや会場に常駐するクリエイターと来場者との対話を通じ互いに刺激し合うことで、新たな発想や次のプロトタイプへとつながる場を生み出します。年々スケールを拡張しながら、都市空間を実験場としてひらき、虎ノ門という街を舞台に、21世紀ならではの新しい「祭り」や「文化」が立ち上がる、東京発の未来を創造する場を目指します。
「TOKYO PROTOTYPE」WEBサイト:https://tokyoprototype.jp
TOKYO PROTOTYPEの見どころ
- 虎ノ門ヒルズ全体を実験場とする都市型フェスティバル⻁ノ門ヒルズの街なかおよび「TOKYO NODE」を舞台に、都市空間そのものを開かれた実験場として活用。街を歩く体験がそのまま鑑賞体験となる都市スケールのクリエイティブフェスティバル。
- 国際的な舞台で注目を集めてきた作品が集結
大阪・関西万博、ミラノデザインウィーク、アルス・エレクトロニカなど、世界的なイベントで注目を集めてきたアーティスト、クリエイターらによる実験的かつ先鋭的な作品が集結するほか、令和6年度文化庁メディア芸術クリエイター育成事業の支援を受けて制作された作品から2作品が出展されます。

- クリエイター・アーティスト・企業・研究機関が領域を越えて参加」
GOOGLE HARDWARE DESIGN STUDIO、ZOZO NEXTなどの企業展示に加え、東京大学 、慶應義塾大学大学院の研究機関まで、計26組の多様な出展者が一堂に会し、テクノロジーと創造性の最前線を可視化。
- AI・ロボティクスなど先端テクノロジーを活用し“未来”の提示
完成形ではなく、思考や試行のプロセスそのものを含んだ「プロトタイプ」を展示。アート、デザイン、テクノロジーが交差する実験的な挑戦を体感できます。
- クリエイター常駐による対話型の展示体験
出展者が会場に常駐。来場者は対話や交流を通じて、作品の背景や思考に直接触れることができ、新たな気づきや次なるコラボレーションが生まれる場となります。
- 年々拡張していく東京発の新しい「祭り」
都市、テクノロジー、創造性が交錯する、21 世紀ならではの文化的実験として、虎ノ門ヒルズから新しい「祭り」や「文化」の立ち上がりを発信します。
開催概要
■日程:2026 年1 月29 日(木)- 1 月31 日(土)■場所:虎ノ門ヒルズ街なか各所およびTOKYO NODE
B2階 ステーションアトリウム・虎ノ門ヒルズカフェ/8階 TOKYO NODE エントランス・
TOKYO NODE LAB・TOKYO NODE CAFE/45階 TOKYO NODE アライバルホール/
46階 TOKYO NODE HALL/49階 TOKYO NODE SKY GARDEN & POOL
■時間:11:00-21:00
■料金:無料
■主催:森ビル株式会社 TOKYO NODE LAB・日本テレビ放送網株式会社
■協力:文化庁
■WEB サイト:https://tokyoprototype.jp
各出展内容
▮ 出展者:GOOGLE HARDWARE DESIGN STUDIOHuman(人を起点に)。Optimistic(前向きに)。Daring(大胆に)。この3つの言葉は、Googleのハードウェアデザインチームを導く指針です。Googleのハードウェアデザインチームは、継続的なサステナビリティへの取り組みの一環として、責任ある素材を用い、長く使い続けられる、思慮深いプロダクトを生み出しています。

▮ 出展者:出展者:株式会社ZOZO NEXT
ZOZO NEXTはファッション領域におけるユーザーの課題を想像しテクノロジーの力で解決することで、より多くの人がファッションを楽しめる世界の創造を目指しています。ファッションを数値化し、科学的に解明するための研究機関「ZOZO研究所」やファッションの未来に影響を与える6領域のテーマでZOZOグループの新規事業の創出を目的とする「MATRIX」などでR&Dをおこなっています。

▮ 出展者:出展者:bit.studio
宙に浮遊する魚が生み出す、超自然を体感できます。

▮ 出展者:TASKO x Abstract Engine
「Tug of Memories」は2021年、コロナ禍で空白となった劇場において、かつての情景を演奏とともに呼び戻す“追憶の舞台装置”として製作されました。ロボットアームが物理的にピアノを手繰り寄せ、レールに記録されたデータを読み取り演奏を行う装置です。人々が集う価値が見直される現在、本作は当時の閉塞と現在の時間を重ね、過去と今の記憶が交差するレイヤーを静かに示します。

▮ 出展者:藤堂高行
鎖に繋がれたロボット犬が、人に襲いかかろうと暴れ狂う姿を、安全圏から眺める作品です。

写真クレジット:Takuma Yamazaki
▮ 出展者:池坊 / BAUMX / enigma
「いのちの多元」蓮が象徴する純粋な命と、都市に広がる多様な命の営み。その間を往復する光と視点の変化を通して、いのちの多層的な姿を体感するインスタレーションです。(いけばな作品:石渡雅史)

▮ 出展者:D2C IMG SRC STUDIO × SoVeC
IMG SRC STUDIOの自社展示「IDEATIONS」を「Satellite」としてTOKYO PROTOTYPEに展開。さらにSoVeC社と協業し、最新技術を応用した作品を制作。XRと感覚刺激による現実と仮想が相互接続する体験、生成AIと知覚的統合による多層的なXR共有体験、そしてユーザーデータや環境をサンプリングし即座にDJミックス可能な感覚拡張型コンテンツを出展します。

▮ 出展者:株式会社ミライセンス
「響き」のリレーと未来への継承~万博で184日間、無数の人々の鼓動を受け取ってきたechorbは、その“響きの遺伝子“をもって、TOKYO PROTOTYPEにやってきます。それは単なるテクノロジーの“再利用“ではなく、記憶と共鳴の継承、そして未来への飛躍です。万博が未来の都市を描いたなら、TOKYO PROTOTYPEでは“未来と文化が交差する場“として、響きによる人と人との共鳴の新しいカルチャーを定義します。

▮ 出展者:Konel Inc. / NTT DX Partner Corporation
「睡眠後進国 日本」日本人の睡眠時間は、先進国を中心とした世界33カ国の中で最下位。未だに十分な睡眠時間を得られておらず、睡眠不足による経済的な損失は計り知れません。オンライン化によって常に大量な情報に晒される現代人にとって、睡眠は世界と断絶できる唯一の時間。私たちは個人の生体データをもとに最適化された音楽と照明によって、パーソナルに眠りを持ち運ぶことができる新しい睡眠システムを提案します。

Photo by YusukeMaekawa
▮ 出展者:HAKUTEN・HAKUTEN CREATIVE
私たちHAKUTEN は、照明、マテリアル、テクノロジーなどを活用し、イベントを通じて新たな体験を創出してきました。「100+ prototypes」とは、プロジェクトの過程で生まれた試作(プロトタイプ)をアーカイブし、創造の循環を生み出すことを目指した取り組み。完成には至らなかった断片にも、試行錯誤の跡やひらめきの種が宿っています。それらを捨てずに蓄積・共有することで、別の誰かの新たな発想につなげることを目的としています。本展示ではその一部を実物展示として公開します。

▮ 出展者:乃村工藝社 未来創造研究所 NOMLAB
NOMLAB では、依頼を受けてから考え始めるのではなく、自ら想像し、これからの空間のアイデアを育てています。今回は、4つのプロトタイプの展示を行います。(Emograf:感情で人と空間をつなぐ、小さな電気でできること:自然由来の小さな電気で植物と人と空間をつなぐ、Sound Seek:音で人と空間をつなぐ、GenerativeTile:陶器とデジタルファブリケーションで空間の未来を描く)

▮ 出展者:130 onethirty | MagnaRecta.inc
中央に置かれたランプ《Helio》は、多層のグリッド構造からなる“コア(核)”として設計されています。その周囲を取り囲むのは、外装一層だけでかたちづくられた人型のマネキンたち──中身を欠いた“シェル(殻)”です。Helio は光を放つランプですが、恒星を模したその光に、人は自然と求めていく様を表現しています。放射状に広がるHelio のグリッドと、薄いシェル構造の人型との対比を通じて、「どこまでが家具で、どこからが身体なのか」「コアとシェルはどちらが主役なのか」という問いの小さなラウンジです。

▮ 出展者:PHIARO CORPORATION
デジタル開発のサンプルとしてMR(Mixed Reality)シミュレータと、リアルのプロトタイプ車両開発のサンプルとしてバギー(デザイン~EV コンポーネンなど)を、ご体感いただけます。加えて、当社の多様なプロトタイプ開発事例を、動画などを通じて幅広く紹介します。

▮ 出展者:mud Inc.
Prompt Racing は、プロンプトから生成されたマシンで競い合う、新感覚のレースゲーム。あらゆるアイデアや妄想がAI によってマシンとして具現化され、常識を超えたレースを展開します。AI の生産性向上や効率化ではなく、創造性を拡張する側面に着目し、自らの創造性がブーストしていく楽しさや喜びを提供します。

▮ 出展者:東京大学五十嵐研究室 / ソフトバンク株式会社 / Takram
「Postrace」は、ショーウィンドウなどでの使用を想定し、衣服を着用して様々なポーズをとることが出来るマネキンロボットです。展示プロトタイプでは、目の前の人の動きを真似するように動作します。人が衣服を着用したのと同じような衣服の変形やしわ、人が服を着て行う様々なポージングを再現するため、人体の自然なシルエットがなるべく崩れない関節構造や、胴体のひねり、肩や骨盤の傾きなどを変化させられる構造になっているのが特徴です。

▮ 出展者:DNP / THRUSTER / 5BLOCKS
コンテンツ・XRコミュニケーションによって、自治体・企業の「場の拡張」と「人の拡張」を実現します。本展示では「場の拡張」として、ARグラス「XREAL」を通じて、ユーザーが視聴している動画や3DCG空間などを、リアルタイムに3D変換し体験できます。また、「人の拡張」としてゲームPFであるMINECRAFTやROBLOXを活用して、職業体験や探求学習も行えます。

▮ 出展者:Abstract Engine
体験者は慣性チェアに身体を委ね、視覚と感覚だけが四足ロボットへ同期します。現実の身体は椅子にとどまりつつ、“ロボットとして振る舞うべき身体”が立ち上がり、体験者の行動パターンを感覚情報と共にデータとして収集し、フィードバックの方法を探ります。本作は、人間と機械の境界を探るプロトタイプです。
機材協賛:ヒビノ株式会社、ヒビノメディアテクニカル株式会社/機材協力 : トヨタ紡織株式会社

▮ 出展者: I.CEBERG | WOW
5名のメゾンによる主要作品と、その制作過程で生まれた個々の物語を組み合わせ、思考の内部をのぞき込むような体験を構成します。来場者は、怪物に向き合うメゾンの旅路を追体験しながら、いつのまにか自身の内側に潜む怪物と向き合うことになるでしょう。

▮ 出展者:Spline Design Hub
本作は機械式腕時計のぜんまいから着想を得た作品です。薄い金属が巻かれたその形は、単なる機構部品にとどまらず、時を駆動する力とリズムを宿す器のように思えました。そっと持ち上げるとわずかな動きを受け取り、今にも鼓動を始めるかのように揺れ動いたのです。 伸縮するアームに支えられた一枚の金属板は刻一刻と形を変え、新たな秩序を生み出し続けます。移ろう螺旋の姿は、目に見えぬ時間の輪郭を静かに描き出しています。

写真クレジット:Daisuke Ohki
▮ 出展者:IE3
1999年のiMacが四半世紀後の世界と出会う。カメラが捉えた身体はブラウン管の中で抽象的なグラフィックへと生まれ変わり、その痕跡はアーカイブとして蓄積されていく。当時では想像もできなかった表現が過去のスクリーンに現れる。技術と時代、過去と現在--重なり合わない複数の層が同期を外れたまま静かに共振する。

▮ 出展者:3 AND PROGRAM
いまは未来。AIが灯した新しい光の中で、人は働くことを忘れ、愛するものに身をゆだねる。肉体は書き換えられ、感覚は衣のようにまとわれ、魂はアバターに宿る。TORIHADA――それは感情を毛先に映す小さな星。鋭く世界に触れ、静かに孤独を抱く。そして今、新たな心の温もりを探している。その手は、あなたのものだろうか。

▮ 出展者:GOO CHOKI PAR
TOKYO PROTOTYPEのアートディレクションを起点に、その思想と視覚表現を“MOTTO(さらに、その先へ)”拡張した作品展示。未知への設計図(ブループリント)を再解釈し、静的な図面から動的な体験へと昇華させる。IE3とのコラボレーションによるPortrait Blueprinterは、来場者の顔をリアルタイムで認識し、この瞬間・この場所でしか生まれないグラフィック作品を生成します。

▮ 出展者:KMD Embodied Media | 慶應義塾大学大学院
身体と空間を拡張し、新たな体験を創造する「身体性メディア」の研究と実践。

▮ 出展者:DLX Design Lab | 東京大学
東京大学生産技術研究所 DLX Design Labと、同研究所の池内研究室による8 年間にわたる4つのバックキャスティングプロジェクトを紹介し、デザインとバイオ分子神経科学の協働から生まれた未来像を示します。
▮ 出展者:xlab(筧康明研究室)| 東京大学
素材の特性や振る舞いにテクノロジーを交差させ、質感を通してナラティブを探究する複数の作品を展示。

▮ 出展者:森田 崇文
MorphFluxは、磁性流体の形状と流れが相互に作用しながら絶えず変化する実体ディスプレイのキネティックインスタレーションです。複数の液体ピクセルが干渉し合い、形や波が絶えず変化することで、一定の状態にとどまらない様子を生み出します。液体の流動的な振る舞いを通して、結びつきと切り離しが繰り返される関係性を想起させるとともに、個々の境界を曖昧にしながら関係し合う、新たな表現のあり方を探ります。

Photo by ikenoya
詳細はWEBページをご覧ください。
「TOKYO PROTOTYPE」WEBサイト:https://tokyoprototype.jp
▮ 同時開催「攻殻機動隊展」との連動:2つの”未来”が虎ノ門で交錯
同時期にTOKYO NODE GALLERYでは、「攻殻機動隊展 ~Ghost and the Shell~」が開催されます。
期間中、虎ノ門ヒルズ一帯では、「TOKYO PROTOTYPE」が提示する未来への実験と、「攻殻機動隊展」が描き続けてきた未来社会のヴィジョンがパラレルに響き合い、都市全体を舞台にした“2つの未来の交錯”を体験いただけます。都市の現在と未来、フィクションとリアルが溶け合う、この期間だけの特別なコラボレーションです。
「攻殻機動隊展~Ghost and the Shell~」WEBサイト:
https://www.tokyonode.jp/sp/exhibition-ghostintheshell/
参考
【TOKYO NODE について】「虎ノ門ヒルズ ステーションタワー」の最上部に位置する新たな情報発信拠点。イベントホール、ギャラリー、レストラン、ルーフトップガーデンなどが集積する、約 10,000 平方メートル の複合発信施設です。 施設内には、ミシュランで星を獲得したシェフによるレストランや、イノベーティブなプレイヤーが集まる研究開発チーム「TOKYO NODE LAB」の活動拠点も。NODE=結節点という名のとおり、テクノロジー、アート、エンターテインメントなどあらゆる領域を超えて、最先端の体験コンテンツ、サービス、ビジネスを生み出し、世界に発信していく舞台となります。
企業プレスリリース詳細へ
PR TIMESトップへ
















